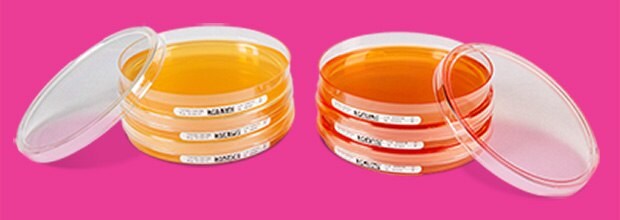
ICR and ICRplus Settle plates For environmental monitoring of microorganisms in cleanrooms and isolators Various petri dishes filled with agar, used for microbial sampling and air monitoring

All-in-One Solution for Air Monitoring
The fully automated Rapid-C+ System is an advanced biofluorescent particle counter (BFPC) for continuous real-time air sampling, featuring a seamlessly integrated unit (C-Catch) for traditional active air sampling. Designed for use in critical areas, the Rapid-C+ System is suitable for gloved and gloveless isolators and can be fully integrated into fill and finish production lines. The system offers the highest accuracy and fault resistance through patented laser technology based on high-resolution light scattering and fluorescent spectroscopy. This productivity-boosting solution allows you to harness the benefits of rapid technologies while ensuring compliance with Good Manufacturing Practices (GMP).

Rapid-C+ System for Microbial Air Monitoring
Benefits
- Continuous real-time monitoring of viable and total particles improves the productivity of filling lines
- Highest reliability and reduction of false alarms increase efficiency
- No manipulation of agar plates inside Grade A areas reduces downtimes and avoids contamination risks
- Compatibility with VHP decontamination increases safety
Advanced Rapid Detection Technologies
The Rapid C+ System is a highly advanced biofluorescence particle counter that utilizes an optimized excitation wavelength to stimulate autofluorescent components within particles, such as NAD(P)H or flavins, and performs differentiated analysis of the resulting laser-induced fluorescence (LIF) emissions. It simultaneously determines particle viability in real-time, using an on-board library of the typical optical fingerprints of microorganisms, while differentiating them from non-viable interfering fluorescent particles.

The autoclavable C-Catch impaction device
The C-Catch device is an independently validated impaction air sampler, which allows continuous microbial monitoring for culturable microorganisms in parallel to the real time fluorescent counting of viable particles. This ensures the probability to perform identification of microorganisms down to species level, e.g. when root cause analysis must be performed. Its user-friendly design allows for easy installation and removal of agar plates without the need to open isolators or RABS, ensuring compliance with GMP and reducing contamination risks.
System Validation and Regulatory Alignment
The Rapid-C+ System, compatible with VHP decontamination, complies with all relevant regulations in leading pharmaceutical markets. Key validations and certifications include:

Rapid-C+ System facilitated by automated continuous data transfer to an EM management software or LIMS
- Validation as an Alternative Rapid Technology according to USP <1223>, Ph. Eur. 5.1.6. and PDA TR No. 33
- Certification of the biological and physical efficiency of the C-Catch impaction unit according to EN 17141
- Compliance with ISO 14644-1 and ISO 21501-4 standards for Total Particle Count
- Compliance with data integrity requirements through automated continuous data transfer to an environmental management (EM) software or laboratory information management systems (LIMS) while acting as a probe
Choosing the Right Agar Plates for Effective Air Monitoring
Using the Rapid-C+ System for environmental monitoring in critical areas requires secure, reliable, and convenient consumables. The easy-to-use ICR and lockable ICRplus agar plates are designed for microbial air monitoring in aseptic production environments, meeting all relevant international standards and regulations, including EU cGMP, FDA Aseptic Guidance, and USP <1116>. These plates come with a standard 30 mL filling volume for continuous monitoring, and there are options available for various neutralizers and enzymes to ensure maximum recovery and utmost reliability. Additionally, both the Rapid C+ instrument and the autoclavable C-Catch impaction device are positioned outside the isolator, enabling users to install and remove plates quickly and safely. Learn more about ICR and ICRplus settle plates, tailored for effective monitoring of microorganisms in cleanrooms and isolators.
To continue reading please sign in or create an account.
Don't Have An Account?